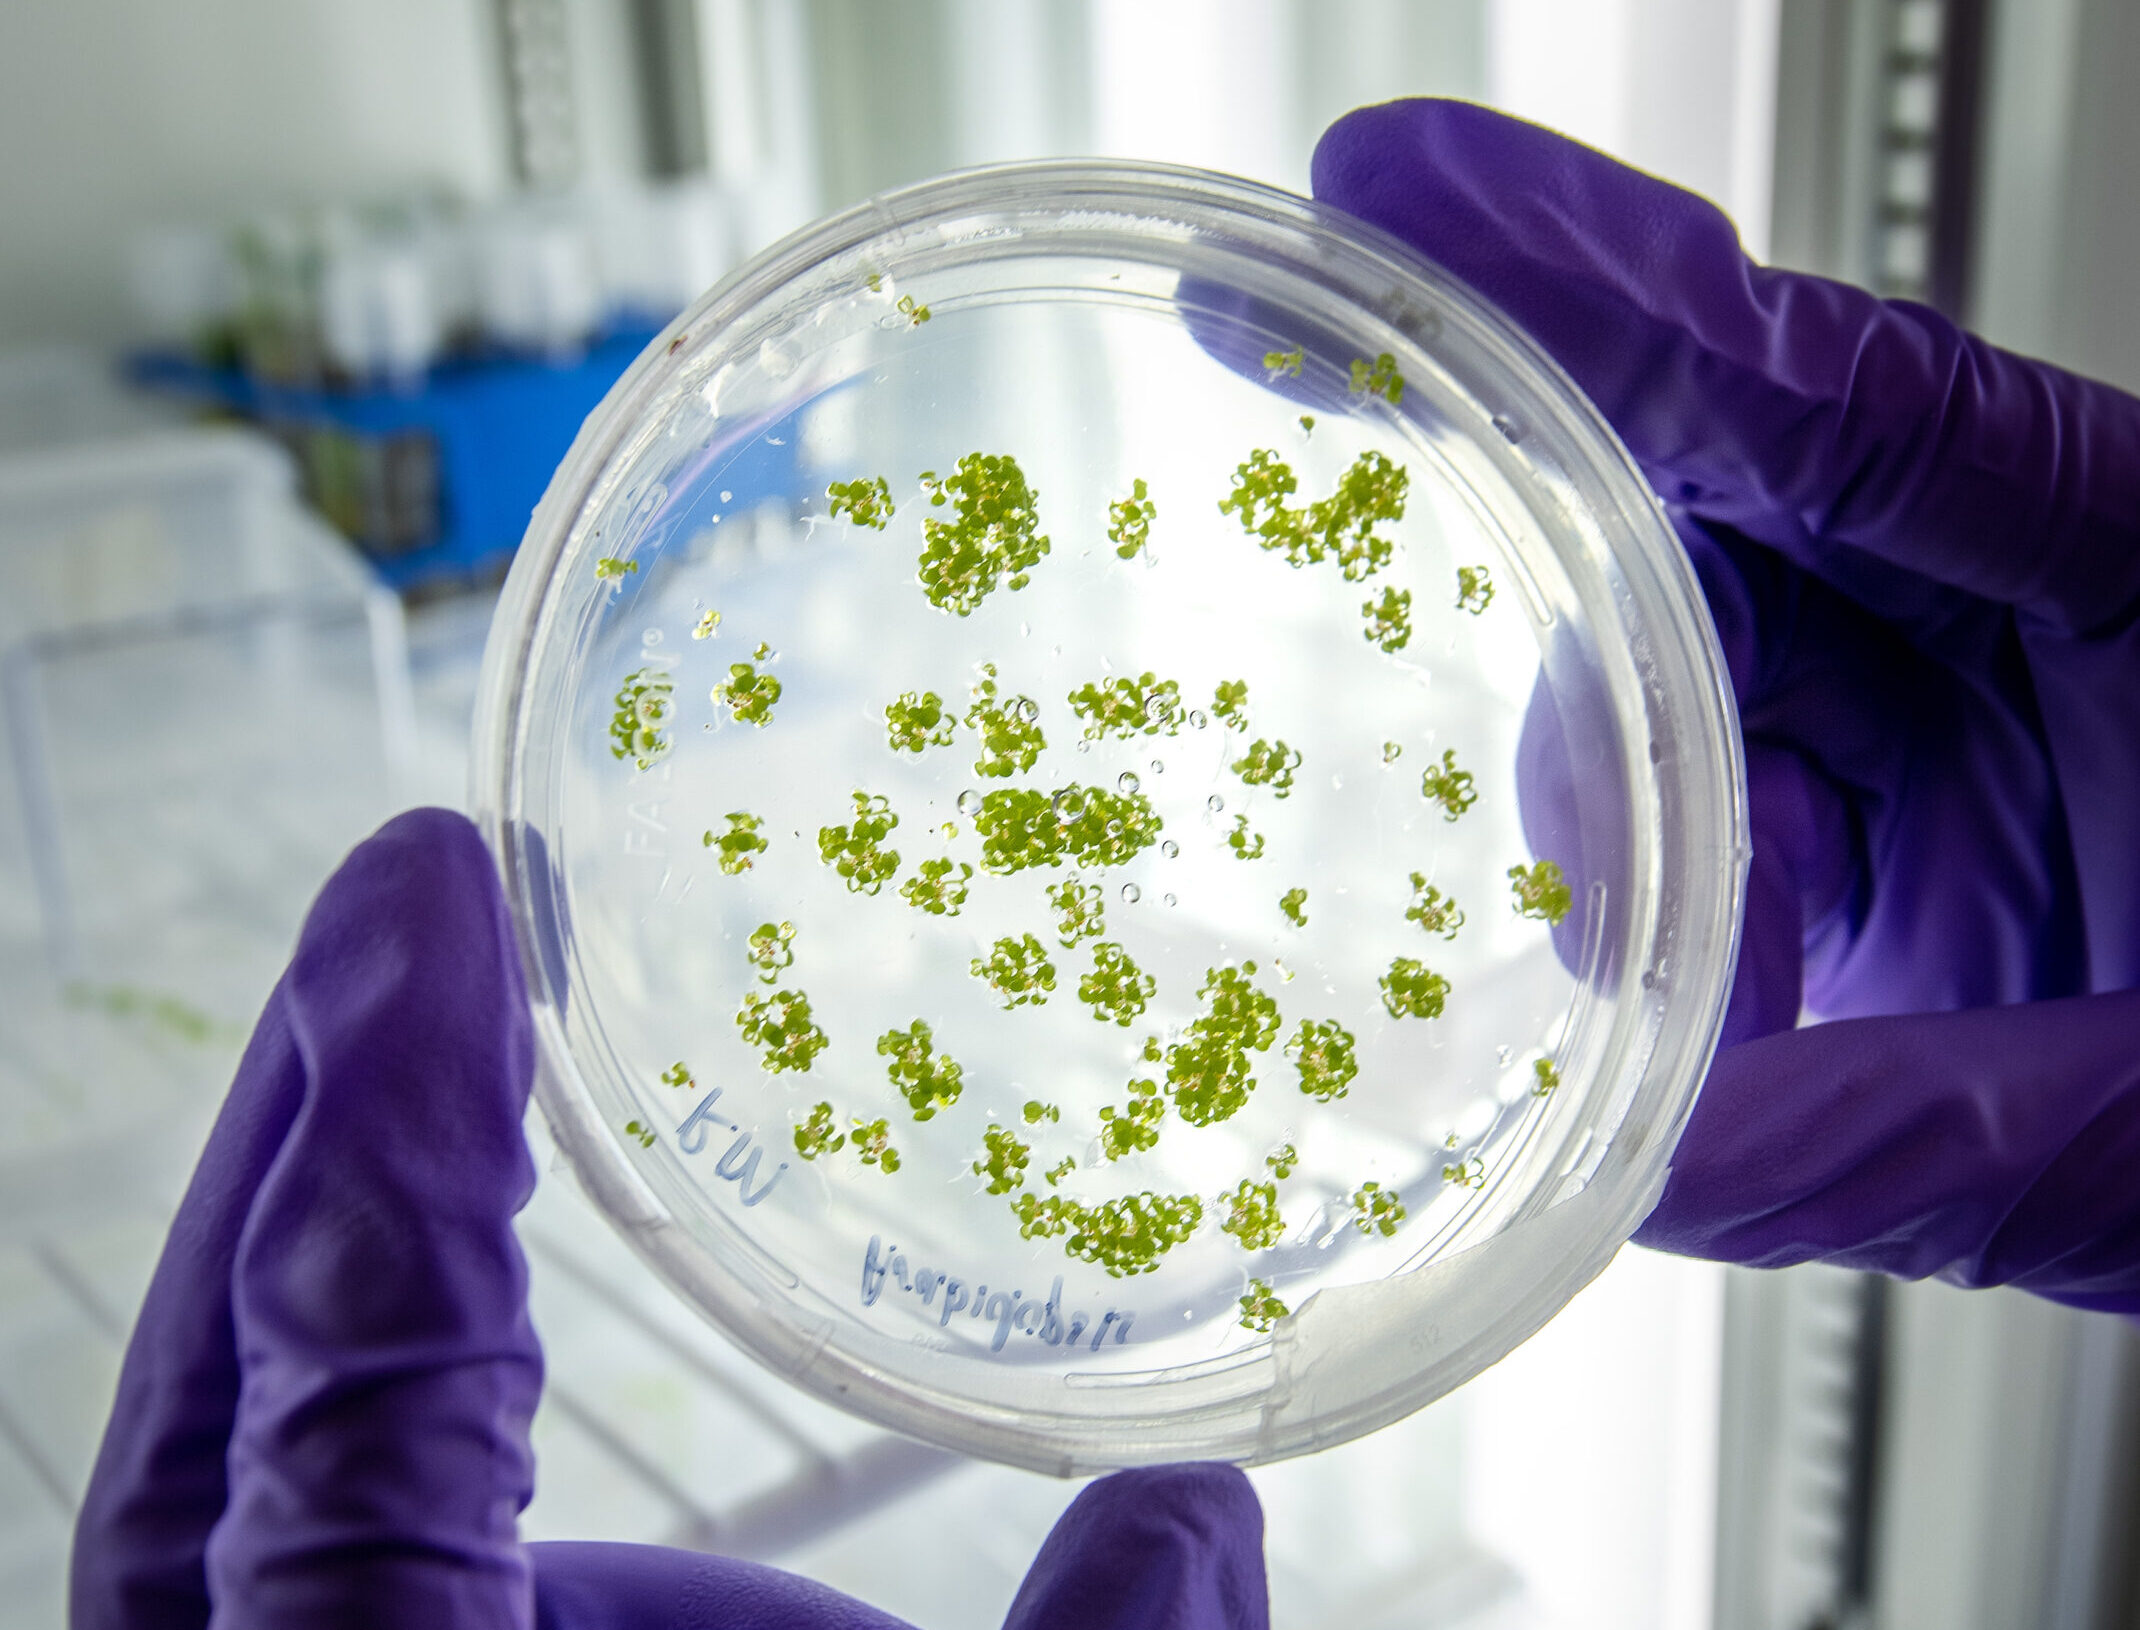

Northen Lab – Metabolomics
Understanding the dynamic reciprocity between exometabolites, microbes, and plants to improve soil health and increase bioenergy crop productivity
About the Lab
The Northen Laboratory at Berkeley Lab is focused on understanding how small molecule organic molecules (metabolites) mediate key processes that govern the behavior of microbiomes, soil health, and bioenergy crop resilience and productivity. Exometabolomic technologies enable us to rapidly identify the metabolic transformations of plants and microbes and environmental and soil metabolomics enables us to match these to what we observe in nature. From this we have learned much about the preferred metabolites (‘substrate preferences’) of diverse microbes, the composition of root exudates across species, and the variation in dissolved organics across the planet.
We use AI/ML and statistical methods to use this rich information to improve our understanding the role of metabolites in mediating key processes and interactions and linking this information to genomics. To test these predictions we construct fabricated ecosystems that enable precise control and monitoring of metabolites, microbes, and plants. These novel capabilities in combination with numerous collaborations enable us to construct mutants to test our predictions. We are now accelerating this research using automation and working with a wide range of collaborators to couple these capabilities with digital twins simulations of our fabricated ecosystems and AI/ML tools to create autonomous experimental capabilities. Together this will help advance a more predictive and replicable microbiome science that will enable us to harness microbes and exogenous metabolites to improve soil and bioenergy crop health.
For current opportunities at the Lawrence Berkeley National Laboratory, please visit LBL Careers.